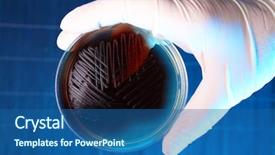
Presentation with bacteria - Presentation having micro organisme - hand in glove holding petri background and a ocean colored foreground
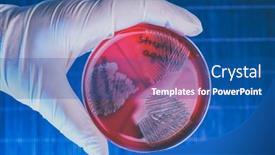
Presentation with bacteria - PPT layouts having hand-in-glove-holding-petri background and a ocean colored foreground

122 Best Bacteria-Themed Templates for PowerPoint and Google Slides
Discover the most fascinating way to present scientific facts about bacteria - explore our incredible collection of 6.7 million PowerPoint templates, featuring stunning options like examining bacteria on a petri backdrop and an ocean-colored foreground or a human anatomy with germs. With three unique presentation titles to inspire your creativity, each template offers a distinct perspective on this microscopic world.
From the wonders of microbiology to the intricacies of human health, our Bacteria PowerPoint templates are designed to captivate your audience's attention and spark their curiosity. Whether you're studying to prepare for a biology exam or simply want to showcase a fascinating scientific concept, we've got you covered with our vast array of themes.
Our templates are meticulously crafted to meet the highest standards of design and compatibility with popular platforms like Google Slides, ensuring a seamless presentation experience. With over 60 slides in each title slide, you'll have ample room to create a visually stunning presentation that will leave your audience engaged and eager for more.
Customize your template to fit your unique style with our array of customizable elements, allowing you to tailor the look and feel of your final product to perfection. And don't worry about compatibility - our templates are available in both widescreen and standard formats, ensuring they'll work effortlessly across different devices and platforms.
Join the thousands of users who have already discovered the power of CrystalGraphics Bacteria PowerPoint templates, and experience the thrill of creating engaging presentations that inspire and educate. Explore our vast collection today, browse through other categories to discover even more incredible themes, or select the perfect template for your specific needs. Download and customize with ease, ensuring you're fully prepared to create a presentation that will leave a lasting impression.
Features & Pricing
Widescreen (16:9) Presentation Templates. Change size...